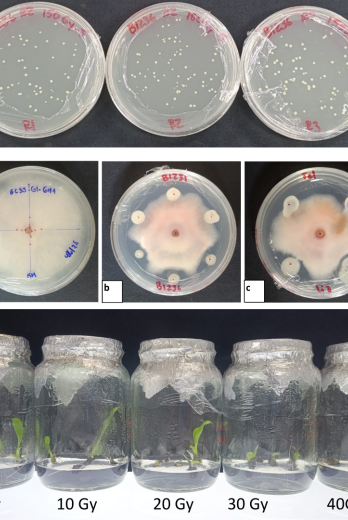
Investigacióm

Sin financiamiento estructural, la ciencia no alcanzará a frenar al Fusarium R4T
Estudio global con aporte de la ESPOL prevé pérdidas de USD 4 billones por el hongo; Ecuador investiga con pocos recursos
El tiempo juega en contra de la industria bananera mundial. Un estudio de 2023 de la Universidad de California en Berkeley, con participación de la Escuela Superior Politécnica del Litoral (ESPOL), estimó que, si no se implementan pronto innovaciones científicas y tecnológicas frente al Fusarium R4T, las pérdidas económicas globales podrían alcanzar los USD 4 billones. El impacto afectaría productores, consumidores y cadenas de suministro por la reducción de oferta y el aumento de precios.
El desafío no es solo desarrollar una variedad resistente, que puede tardar entre cinco y diez años, sino garantizar su aprobación regulatoria y acceso al productor. Freddy Magdama, jefe del Departamento de Fitopatología y Microbiología del Centro de Investigaciones Biotecnológicas del Ecuador de la ESPOL, aclara: “No solo es el tema y el tiempo que toma desarrollar una variedad. Sino está el tema de adopción, cuánto toma para que un productor pueda acceder a una variedad porque aquí viene el tema regulatorio y ese tema regulatorio a veces demora muchísimo o retarda que esas tecnologías lleguen pronto.”
Además, la ESPOL trabaja en un estudio para proyectar el impacto económico del R4T a nivel nacional, ante un panorama que ha cambiado con la llegada del patógeno al país.
Variedades resistentes
Una de las principales líneas de investigación en la ESPOL se centra en el desarrollo de variedades resistentes al Fusarium R4T. A través de mutagénesis química, los investigadores han generado miles de plantas mutantes de banano, sometiendo el material vegetal a agentes que producen cambios en el ADN. El objetivo es identificar variantes que, tras ser expuestas al patógeno, muestren resistencia.
“Hemos venido trabajando con esta técnica desde hace algunos años. Ya tenemos nuestro primer lote ensayado en campo y estamos en el proceso de selección de algunas variantes”, explica Magdama. De un primer lote de cerca de 5.000 mutantes, los científicos han observado variaciones en características como el tamaño del racimo y la forma del fruto. El siguiente paso es la fenotipificación, es decir, la evaluación detallada para identificar candidatos con potencial resistencia.
El proceso, sin embargo, es incierto y costoso. “Esta técnica es prácticamente una lotería, porque no sabes en qué mutante vas a tener el candidato ideal con resistencia a Fusarium”, señala el investigador. Por ello, el equipo busca recursos adicionales para generar nuevos lotes y ampliar las probabilidades de éxito.
El material deberá ser evaluado en Colombia, en colaboración con Agrosavia, una de las pocas instituciones de la región con capacidad para realizar pruebas con Fusarium R4T. “El espacio es limitado y toma su tiempo. Es solo cuestión de que los materiales puedan llegar y ser fenotipados”, indica Magdama.
En paralelo, la ESPOL desarrolla un proyecto con la Agencia Internacional de Energía Atómica para generar nuevas variedades mediante irradiación con rayos gamma. En este caso, el agente mutagénico es físico y proviene de una fuente de cobalto-60. El principio es similar: generar miles de plantas, exponerlas al patógeno y seleccionar aquellas que sobrevivan. El trabajo incluye tanto banano como plátano, este último clave para la seguridad alimentaria del país.
Microorganismos: aliados, no soluciones únicas
Otra línea de investigación se enfoca en el uso de microorganismos nativos con actividad antagonista frente al Fusarium. El equipo ha seleccionado cepas de Bacillus, Trichoderma y actinomicetos, caracterizadas por su capacidad de inhibir al patógeno. Algunas de estas cepas también han sido sometidas a irradiación para potenciar su efecto.
La meta es desarrollar productos biológicos que puedan ser aplicados en campo. Sin embargo, Magdama es enfático en marcar límites. “Los microorganismos son una herramienta útil, pero no son la panacea”, afirma. La efectividad de estos agentes depende de múltiples factores, como la carga del patógeno en el suelo, el estado de la plantación y las prácticas de manejo.
El enfoque según Magdama debe ser de manejo integrado. “Reducir la carga del patógeno implica fertilización adecuada, manejo de humedad, drenaje, control de malezas y el uso de variedades tolerantes o resistentes".
Nudo crítico
A pesar de la diversidad de investigaciones en marcha, Magdama identifica un problema de fondo. “El tema es más estructural”, afirma. Según explica, tanto la ESPOL como otras instituciones, como el INIAP, han desarrollado investigación, pero de forma puntual y fragmentada. Los fondos suelen ser limitados, de corta duración o provenientes del exterior o del sector privado.
“Damos esos pequeños pasitos, pero cuando nos enfrentamos a problemáticas grandes que ameritan programas estructurales a largo plazo, no son suficientes”, señala. Desarrollar una variedad resistente puede tomar entre cinco y diez años, dependiendo de la tecnología disponible y de las restricciones regulatorias. En Ecuador, herramientas como la edición genética o la transformación genética enfrentan fuertes restricciones.
Sin financiamiento sostenido, los proyectos no logran madurar. “Si no hay fondos que nos permitan concentrarnos en desarrollar estos productos, difícilmente los vamos a hacer realidad”, advierte. Por ello, plantea la necesidad de articular esfuerzos entre Estado, academia y sector productivo, con una visión de largo plazo.
Si quieres leer esta y más noticias, suscríbete a EXPRESO. SUSCRÍBETE AQUÍ